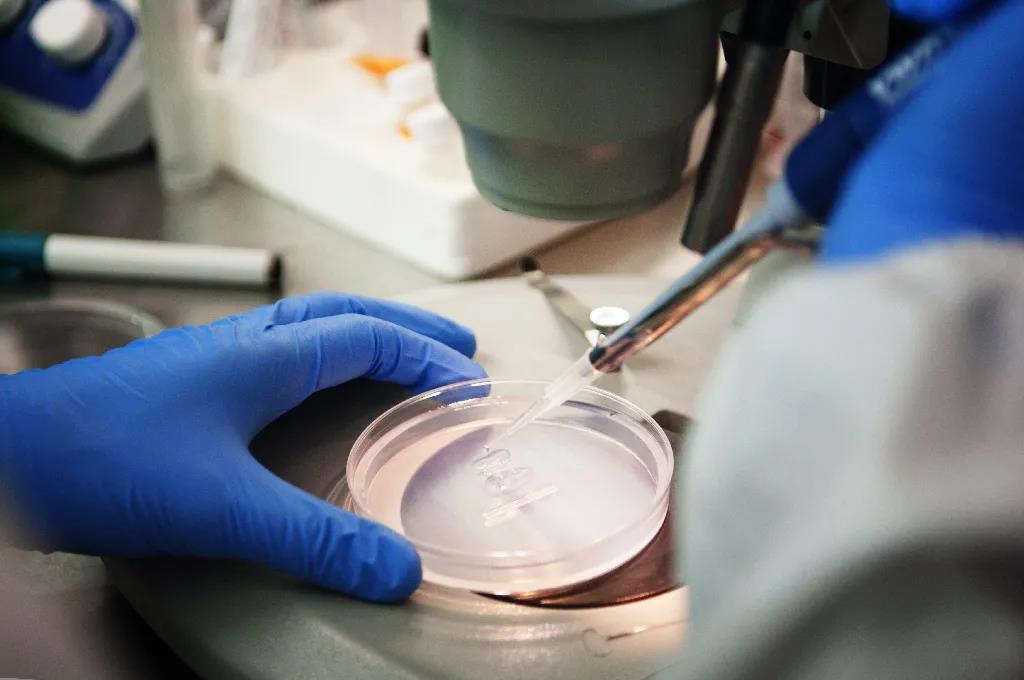

近日,奥维奥与莱凯医疗器械(北京)有限公司(以下简称为莱凯医疗)正式启动AVA Vstore和SAP Analytics Cloud项目,莱凯医疗业务部、IT部、财务部、市场部以及奥维奥实施团队, 共同参加了本次启动大会。

项目背景
莱凯医疗成立于1997年,是目前国内泌尿外科专业的设备、耗材和解决方案的供应商之一。向国内各级医院、医疗机构泌尿外科提供疾病预防、治疗和护理过程管理的系列服务。公司总部设在北京,而其销售、维护则延伸到了全国各地。
2013年,莱凯医疗选择了奥维奥提供的医疗器械行业解决方案,通过SAP ERP系统帮助企业建立完善的质量管理、成本管控体系,树立自动化、标准化的工作流程,实现又快、又好的高质量发展。
目前,莱凯医疗公司以优质的仓储条件、雄厚的资金实力、完善的销售及售后服务使公司现与全国各主要医疗器械生产厂家、与国内外上千家医疗院及社会有关部门都建立了相互支持、彼此信任的良好关系,并形成了一定规模的购进、营销网络,起到了预防各种公共突发事件,如灾情、疫情的作用。
项目目标
伴随着业务版图的快速扩张,莱凯医疗迫切需要对内部千余家代理商进行精细化整合管理。基于同奥维奥多年合作积累的信任与认可,莱凯医疗决定再次与奥维奥合作,引入AVA Vstore和SAP Analytics Cloud两个系统。

莱凯医疗项目组负责人徐婷婷对本次合作充满了期待:“这次合作是莱凯医疗与奥维奥的再次联手。前几年,奥维奥专业的实施和服务团队帮助莱凯医疗实现了数字化转型,优化企业运营结构,全面提高了工作效率。现在,我们计划在SAP ERP的基础上,加入AVA Vstore和SAP Analytics Cloud两个系统,实现财务业务数据实时分析,转化数据资产,解决销售业务管理难题,使企业管理更加规范化、标准化,以保证企业的未来发展。”

奥维奥产品总监姜东针对莱凯医疗管理系统升级表示:“AVA Vstore作为全渠道销售解决方案,可以帮助莱凯医疗进行科学化品类管理,标准化定价管理,从产品销售计划和预算制定,到全渠道销售智能化管理,以及产品售后维护与客户关系管理,实现企业全业务链条清晰管控。在企业互联网时代下,通过AVA Vstore数字化的运营和管理工具,将加速莱凯医疗全面数字化转型升级。”

奥维奥商务智能产品经理刘春光听取莱凯医疗的业务需求后表示:“SAC作为SAP将商务智能、计划、预测集于一体的 SaaS 云解决方案,能够为莱凯医疗解决目前的数据分析难题。SAC的财务数据报表,可以从维度和深度两方面改善现有Excel报表缺陷,做到更专业化的数据分析。另外,通过SAC系统能够把预算做到市场、财务、人力资源的全员参与,在减少人力资源投入的同时,系统填报合规化,工作流程规范化。并且SAC支持价值动因数模型,为用户提供假设分析,借助人工智能驱动下的实时洞察,极大的方便决策层更快地制定有把握的决策。”
未来,相信在奥维奥的帮助下,莱凯医疗将构建ERP(SAP B1)+顺丰物流(AVA Addon)+CRM( AVA Vstore )+报表分析( SAC )完整的信息系统框架,全面梳理提升企业经营水平,多方位支持企业完成数字化转型升级,助力莱凯医疗在市场竞争中全力冲刺。
会议现场掠影






